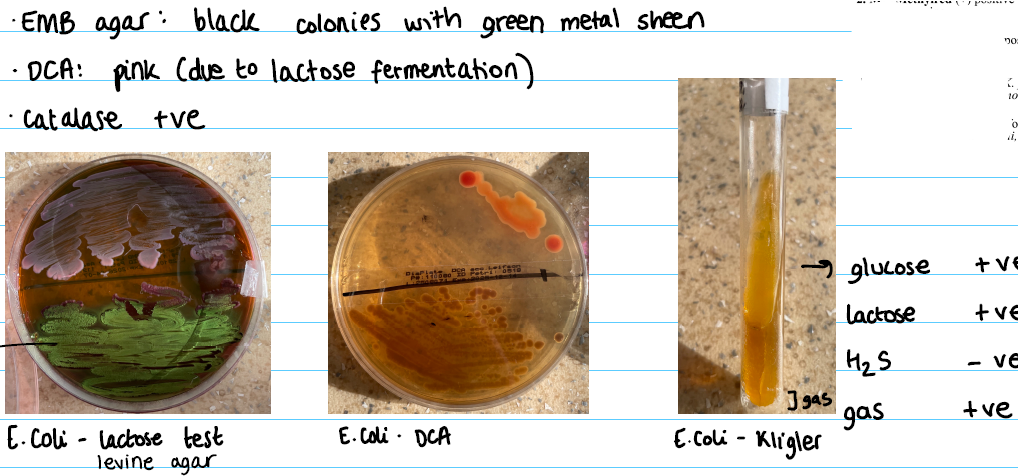
<p><strong>EMB agar:</strong></p><ul><li><p>black colonies with green metal sheen</p></li></ul><p><strong>DCA agar:</strong></p><ul><li><p>pink (due to lactose fermentation)</p></li></ul><p><strong>Klingler:</strong></p><ul><li><p>Yellow everywhere</p></li></ul><p></p>

1/12
Group 20 2025
Name | Mastery | Learn | Test | Matching | Spaced | Call with Kai |
|---|
No analytics yet
Send a link to your students to track their progress
Morphology
scattered, short enteric rods
Staining
Gram -
Types
E.coli
Salmonella
Shingella
Proteus
Klebsiella
Pseudomonas
Pathogenic factor
Endotoxins
rare: Exotoxins
Cultivation (General)
Deoxychocolate agar:
pink - lactose fermenting (E.coli/klebsiella)
colorless - non-lactose fermenting (Salmonella, Shingella)
Salmonella: Black centre (H2S production)
Shingella: colorless with no H2S production
Levine agar:
lactose fermenting: ink blue colonies (E.coli/klebsiella)
lactose non-fermenting: colorless (Salmonella/Shingella)
Cultivation E.coli
EMB agar:
black colonies with green metal sheen
DCA agar:
pink (due to lactose fermentation)
Klingler:
Yellow everywhere
Cultivation Salmonella
EMB agar /DCA agar
black spots on agar
Mac Conkey agar
negative -ve
Selenite broth:
Salmonella: red
Sterile: transparent
Kligler Agar:
Red
Black ring
Yellow

Cultivation Proteus
Kligler Agar:
completely black

Cultivation Shingella/Klebsiella
Kligler Agar:
Red
Yellow

Specimen
feces
urine
blood
sputum
wound swab
Symptoms
E.coli:
Diarrhea
abdominal cramps
fever
Salmonella:
Diarrhea
fever
abdominal cramps
vomiting
Klebsiella:
Pneumonia
Pseudomonas:
wound infections
Antibiotics
Amoxicillin
Fluorchinolones
Vaccine
only Salmonella (Typhoid)